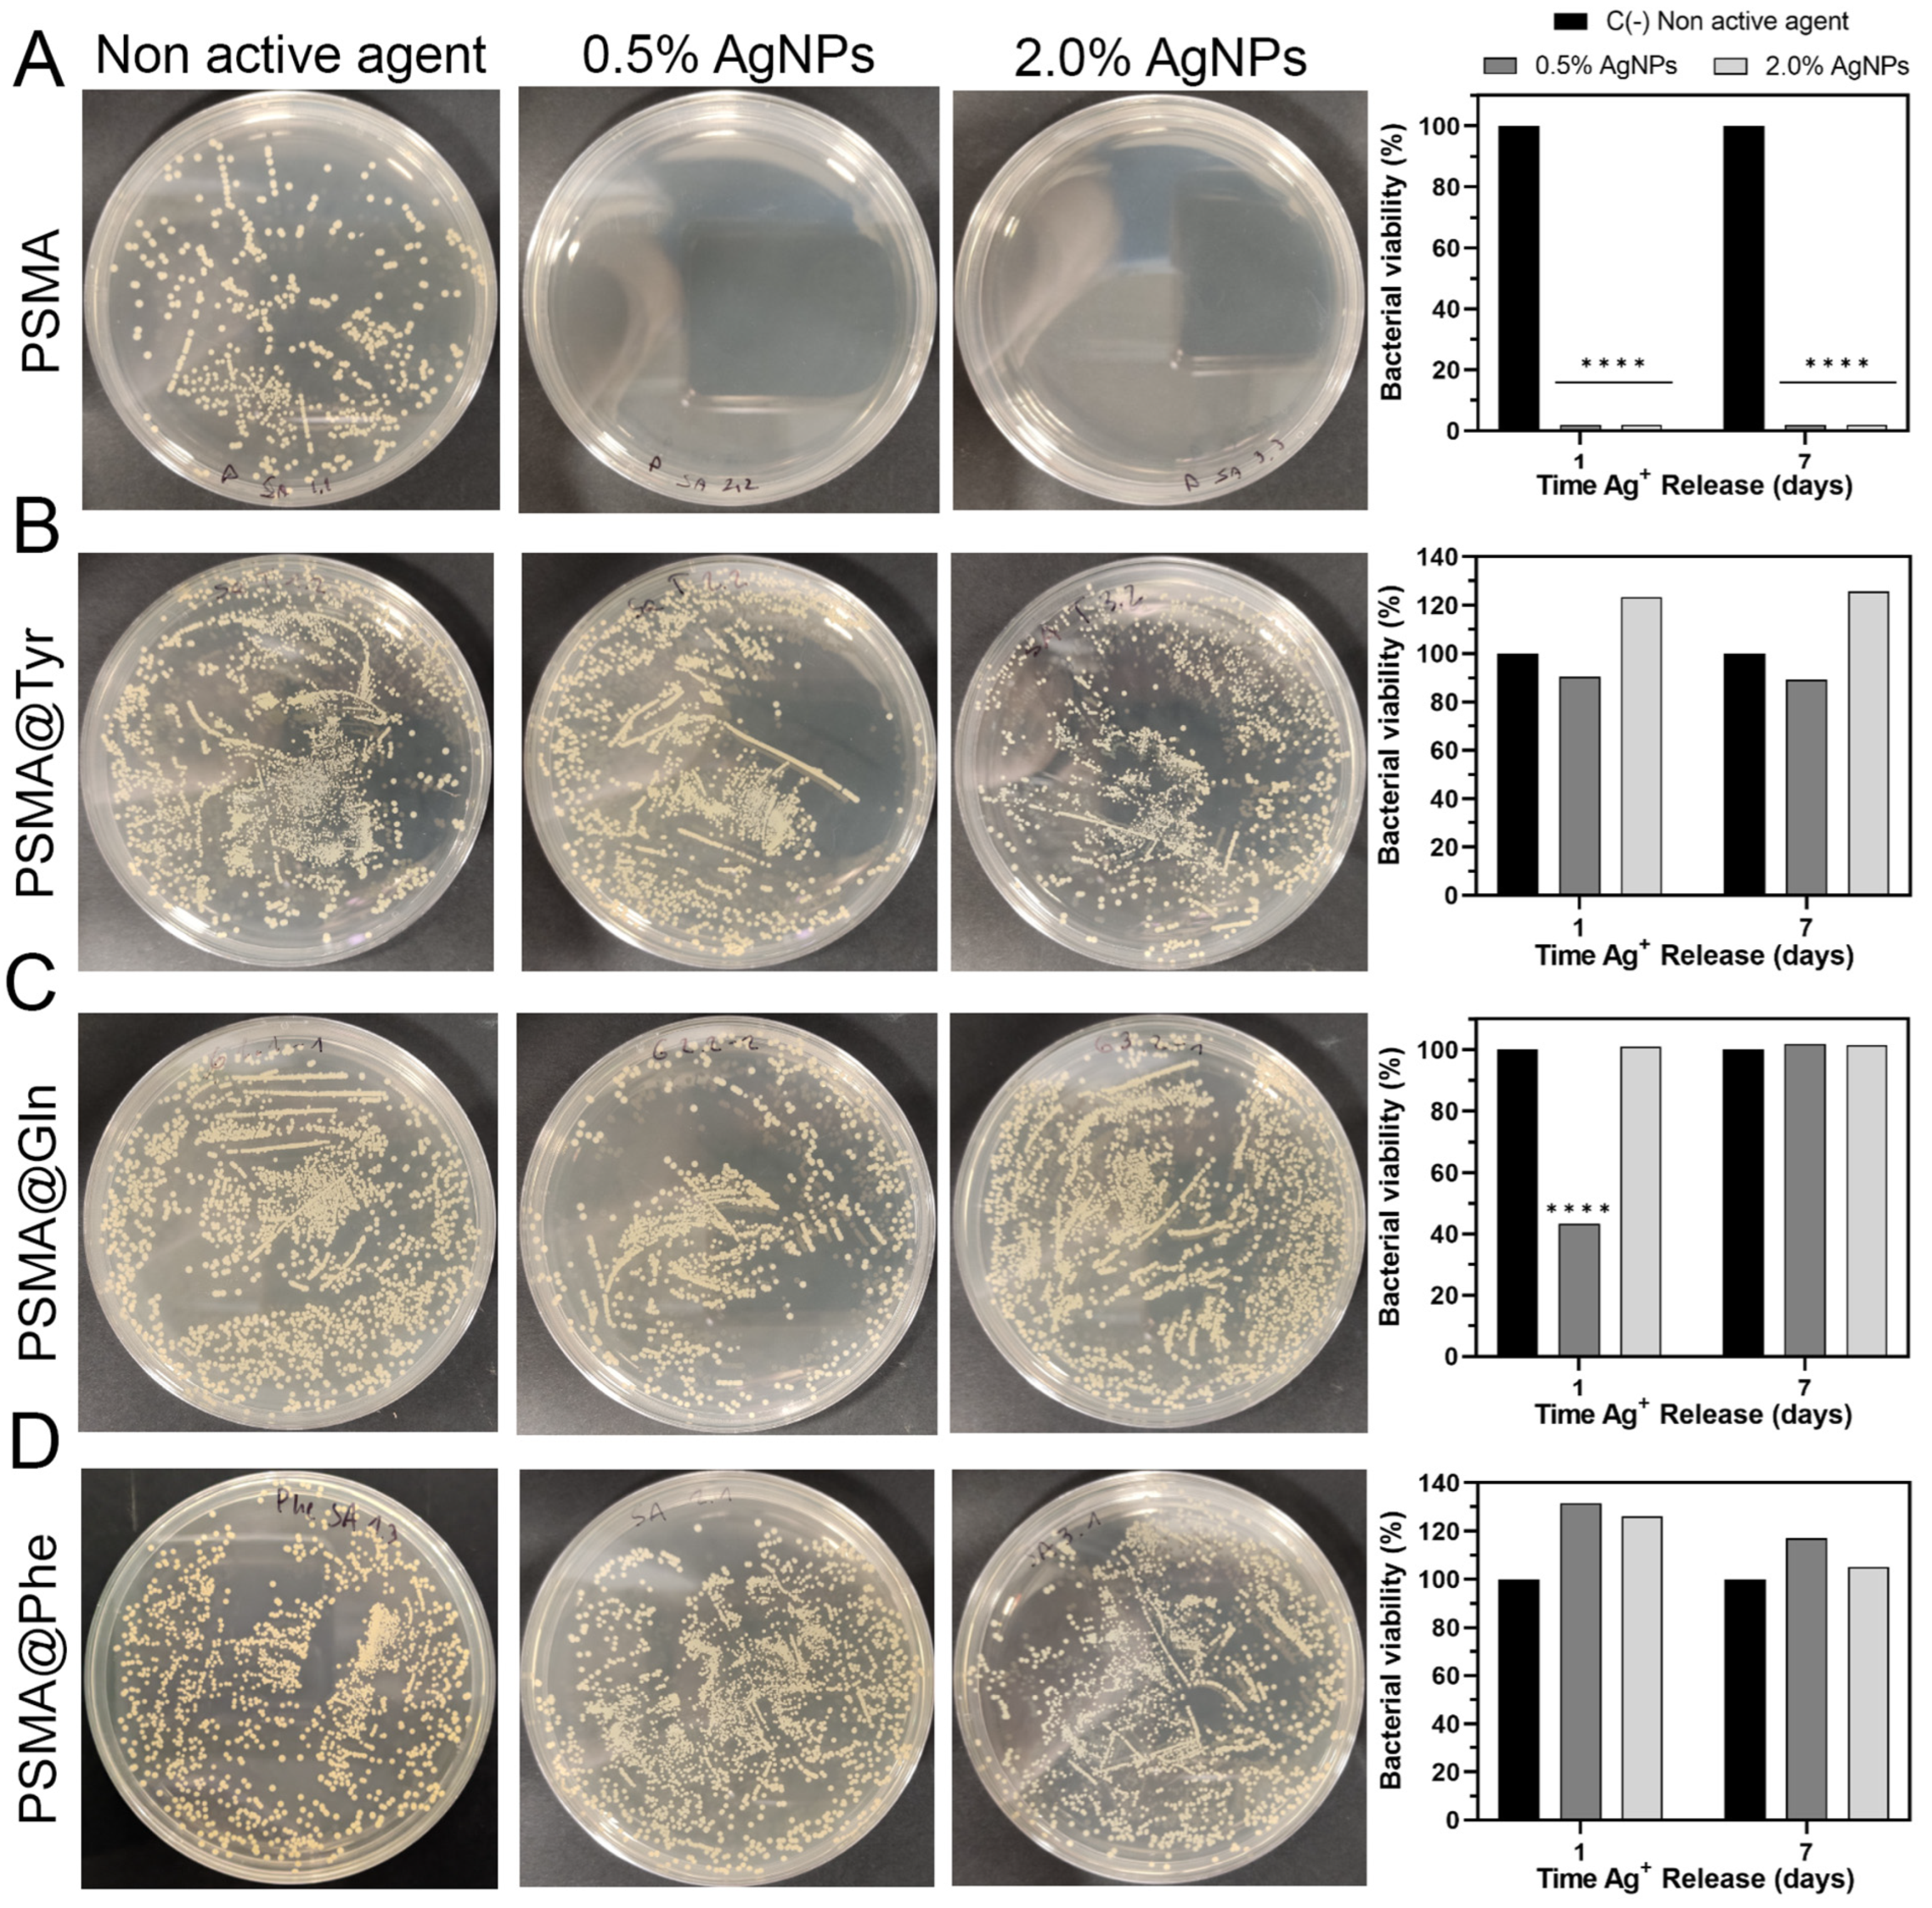
Pharmaceutics 15 01659 g012

Wettability of Amino Acid-Functionalized PSMA Electrospun Fibers for the Modulated Release of Active Agents and Its Effect on Their Bioactivity
Abstract
1. Introduction
2. Materials and Methods
2.1. Materials
2.2. Functionalization of PSMA with Amino Acids
2.3. Synthesis of AgNPs
2.4. Elaboration and Characterization of Polymer Mats
2.5. Wettability of Polymer Mats
2.5.1. Contact Angle
2.5.2. Water Uptake
2.6. Release of AgNPs from Polymer Mats
Analytical Methods for Ag+ Release Curves
2.7. C. officinalis Release from Polymer Mats
2.8. Antibacterial Test of Polymer Mats
2.9. Cytotoxicity Assay of Polymer Meses
2.10. Hemolysis Assay of Mats
3. Results and Discussion
3.1. Functionalization of PSMA with Amino Acids
3.2. Characterization of PSMA and PSMAf Mats
3.3. Wettability of Polymer Mats
3.3.1. Contact Angle
3.3.2. Water Uptake Capacity of the Mats
3.4. Release of Silver Ions from the Mats
3.5. Release of C. officinalis from the Mats
3.6. Antibacterial Activity of Polymer Mats
3.7. Cytotoxicity of Polymer Mats
3.8. Hemolytic Activity of Polymer Mats
4. Conclusions
Supplementary Materials
Author Contributions
Funding
Institutional Review Board Statement
Informed Consent Statement
Data Availability Statement
Acknowledgments
Conflicts of Interest
References
- Lazarus, G.S.; Cooper, D.M.; Knighton, D.R.; Margolis, D.J.; Percoraro, R.E.; Rodeheaver, G.; Robson, M.C. Definitions and guidelines for assessment of wounds and evaluation of healing. Wound Repair Regen. 1994, 2, 165–170. [Google Scholar] [CrossRef] [PubMed]
- Rahim, K.; Saleha, S.; Zhu, X.; Huo, L.; Basit, A.; Franco, O.L. Bacterial contribution in chronicity of wounds. Microb. Ecol. 2017, 73, 710–721. [Google Scholar] [CrossRef] [PubMed]
- Nussbaum, S.R.; Carter, M.J.; Fife, C.E.; DaVanzo, J.; Haught, R.; Nusgart, M.; Cartwright, D. An economic evaluation of the impact, cost, and medicare policy implications of chronic nonhealing wounds. Value Health 2018, 21, 27–32. [Google Scholar] [CrossRef]
- Chan, B.; Cadarette, S.; Wodchis, W.; Wong, J.; Mittmann, N.; Krahn, M. Cost-of-illness studies in chronic ulcers: A systematic review. J. Wound Care 2017, 26, S4–S14. [Google Scholar] [CrossRef] [PubMed]
- Dhivya, S.; Padma, V.V.; Santhini, E. Wound dressings–A review. BioMedicine 2015, 5, 22. [Google Scholar] [CrossRef]
- Li, Z.; Milionis, A.; Zheng, Y.; Yee, M.; Codispoti, L.; Tan, F.; Poulikakos, D.; Yap, C.H. Superhydrophobic hemostatic nanofiber composites for fast clotting and minimal adhesion. Nat. Commun. 2019, 10, 5562. [Google Scholar] [CrossRef]
- Du, Z.; Cao, G.; Li, K.; Zhang, R.; Li, X. Nanocomposites for the delivery of bioactive molecules in tissue repair: Vital structural features, application mechanisms, updated progress and future perspectives. J. Mater. Chem. B 2020, 8, 10271–10289. [Google Scholar] [CrossRef]
- Afsharian, Y.P.; Rahimnejad, M. Bioactive electrospun scaffolds for wound healing applications: A comprehensive review. Polym. Test. 2020, 93, 106952. [Google Scholar] [CrossRef]
- Liu, Y.; Li, T.; Han, Y.; Li, F.; Liu, Y. Recent Development of Electrospun wound dressing. Curr. Opin. Biomed. Eng. 2020, 17, 100247. [Google Scholar] [CrossRef]
- Ghomi, E.R.; Khosravi, F.; Neisiany, R.E.; Shakiba, M.; Zare, M.; Lakshminarayanan, R.; ChellapPan, V.; Abdouss, M.; Ramakrishna, S. Advances in electrospinning of aligned nanofiber scaffolds used for wound dressings. Curr. Opin. Biomed. Eng. 2022, 22, 100393. [Google Scholar] [CrossRef]
- Chen, K.; Hu, H.; Zeng, Y.; Pan, H.; Wang, S.; Zhang, Y.; Shi, L.; Tan, G.; Pan, W.; Liu, H. Recent advances in electrospun nanofibers for wound dressing. Eur. Polym. J. 2022, 178, 111490. [Google Scholar] [CrossRef]
- Xu, H.; Zhang, F.; Wang, M.; Lv, H.; Yu, D.G.; Liu, X.; Shen, H. Electrospun hierarchical structural films for effective wound healing. Biomater. Adv. 2022, 136, 212795. [Google Scholar] [CrossRef] [PubMed]
- Ding, J.; Zhang, J.; Li, J.; Li, D.; Xiao, C.; Xiao, H.; Yang, H.; Zhuang, X.; Chen, X. Electrospun polymer biomaterials. Prog. Polym. Sci. 2019, 90, 1–34. [Google Scholar] [CrossRef]
- Dos Santos, D.M.; Correa, D.S.; Medeiros, E.S.; Oliveira, J.E.; Mattoso, L.H. Advances in functional polymer nanofibers: From spinning fabrication techniques to recent biomedical applications. ACS Appl. Mater. Interfaces 2020, 12, 45673–45701. [Google Scholar] [CrossRef] [PubMed]
- Dong, Y.; Zheng, Y.; Zhang, K.; Yao, Y.; Wang, L.; Li, X.; Yu, J.; Ding, B. Electrospun nanofibrous materials for wound healing. Adv. Fiber Mater. 2020, 2, 212–227. [Google Scholar] [CrossRef]
- Homaeigohar, S.; Boccaccini, A.R. Antibacterial biohybrid nanofibers for wound dressings. Acta Biomater. 2020, 107, 25–49. [Google Scholar] [CrossRef]
- Homaeigohar, S.; Tsai, T.Y.; Zarie, E.S.; Elbahri, M.; Young, T.H.; Boccaccini, A.R. Bovine Serum Albumin (BSA)/polyacrylonitrile (PAN) biohybrid nanofibers coated with a biomineralized calcium deficient hydroxyapatite (HA) shell for wound dressing. Mater. Sci. Eng. C 2020, 116, 111248. [Google Scholar] [CrossRef]
- Homaeigohar, S.; Monavari, M.; Koenen, B.; Boccaccini, A.R. Biomimetic biohybrid nanofibers containing bovine serum albumin as a bioactive moiety for wound dressing. Mater. Sci. Eng. C 2021, 123, 111965. [Google Scholar] [CrossRef]
- Tottoli, E.M.; Chiesa, E.; Ceccarelli, G.; Pisani, S.; Bruni, G.; Genta, I.; Conti, B.; Dorati, R. BioFiber: An advanced fibrous textured dressing to manage exudate in severe wounds. Int. J. Pharm. 2022, 625, 122073. [Google Scholar] [CrossRef]
- Liu, X.; Xu, H.; Zhang, M.; Yu, D.G. Electrospun medicated nanofibers for wound healing. Membranes 2021, 11, 770. [Google Scholar] [CrossRef]
- Stoica, A.E.; Chircov, C.; Grumezescu, A.M. Nanomaterials for wound dressings: An up-to-date overview. Molecules 2020, 25, 2699. [Google Scholar] [CrossRef] [PubMed]
- Siepmann, J.; Siegel, R.A.; Siepmann, F. Diffusion Controlled Drug Delivery Systems. In Fundamentals and Applications of Controlled Release Drug Delivery; Springer: Boston, MA, USA, 2011; pp. 127–152. [Google Scholar] [CrossRef]
- Rosilio, V.; Costa, M.D.L.; Baszkin, A. Wettability of drug loaded polymer matrices. J. Dispers. Sci. Technol. 1998, 19, 821–841. [Google Scholar] [CrossRef]
- Bedair, T.M.; Yu, S.J.; Im, S.G.; Park, B.J.; Joung, Y.K.; Han, D.K. Effects of interfacial layer wettability and thickness on the coating morphology and sirolimus release for drug-eluting stent. J. Colloid Interface Sci. 2015, 460, 189–199. [Google Scholar] [CrossRef] [PubMed]
- Mahdieh, Z.; Mitra, S.; Holian, A. Core–Shell Electrospun Fibers with an Improved Open Pore Structure for Size-Controlled Delivery of Nanoparticles. ACS Appl. Polym. Mater. 2020, 2, 4004–4015. [Google Scholar] [CrossRef]
- Maleki Dizaj, S.; Sharifi, S.; Jahangiri, A. Electrospun nanofibers as versatile platform in antimicrobial delivery: Current state and perspectives. Pharm. Dev. Technol. 2019, 24, 1187–1199. [Google Scholar] [CrossRef]
- Boonkaew, B.; Kempf, M.; Kimble, R.; Supaphol, P.; Cuttle, L. Antimicrobial efficacy of a novel silver hydrogel dressing compared to two common silver burn wound dressings: Acticoat™ and PolyMem Silver®. Burns 2014, 40, 89–96. [Google Scholar] [CrossRef]
- Hong, K.H. Preparation and properties of electrospun poly (vinyl alcohol)/silver fiber web as wound dressings. Polym. Eng. Sci. 2007, 47, 43–49. [Google Scholar] [CrossRef]
- Augustine, R.; Hasan, A.; Nath, V.Y.; Thomas, J.; Augustine, A.; Kalarikkal, N.; Al Moustafa, A.E.; Thomas, S. Electrospun polyvinyl alcohol membranes incorporated with green synthesized silver nanoparticles for wound dressing applications. J. Mater. Sci. Mater. Med. 2018, 29, 163. [Google Scholar] [CrossRef]
- Thinakaran, S.; Loordhuswamy, A.; Rengaswami, G.V. Electrophoretic deposition of chitosan/nano silver embedded micro sphere on centrifugal spun fibrous matrices–A facile biofilm resistant biocompatible material. Int. J. Biol. Macromol. 2020, 148, 68–78. [Google Scholar] [CrossRef]
- Fahimirad, S.; Ajalloueian, F. Naturally-derived electrospun wound dressings for target delivery of bio-active agents. Int. J. Pharm. 2019, 566, 307–328. [Google Scholar] [CrossRef]
- Givol, O.; Kornhaber, R.; Visentin, D.; Cleary, M.; Haik, J.; Harats, M. A systematic review of Calendula officinalis extract for wound healing. Wound Repair Regen. 2019, 27, 548–561. [Google Scholar] [CrossRef] [PubMed]
- Buzzi, M.; De Freitas, F.; de Barros Winter, M. Therapeutic effectiveness of a Calendula officinalis extract in venous leg ulcer healing. J. Wound Care 2016, 25, 732–739. [Google Scholar] [CrossRef] [PubMed]
- Rad, Z.P.; Mokhtari, J.; Abbasi, M. Calendula officinalis extract/PCL/Zein/Gum arabic nanofibrous bio-composite scaffolds via suspension, two-nozzle and multilayer electrospinning for skin tissue engineering. Int. J. Biol. Macromol. 2019, 135, 530–543. [Google Scholar] [CrossRef]
- Nicolaus, C.; Junghanns, S.; Hartmann, A.; Murillo, R.; Ganzera, M.; Merfort, I. In vitro studies to evaluate the wound healing properties of Calendula officinalis extracts. J. Ethnopharmacol. 2017, 196, 94–103. [Google Scholar] [CrossRef] [PubMed]
- Miguel, S.P.; Figueira, D.R.; Simões, D.; Ribeiro, M.P.; Coutinho, P.; Ferreira, P.; Correia, I.J. Electrospun polymeric nanofibres as wound dressings: A review. Colloids Surf. B Biointerfaces 2018, 169, 60–71. [Google Scholar] [CrossRef]
- Gao, C.; Zhang, L.; Wang, J.; Jin, M.; Tang, Q.; Chen, Z.; Cheng, Y.; Yang, R.; Zhao, G. Electrospun nanofibers promote wound healing: Theories, techniques, and perspectives. J. Mater. Chem. B 2021, 9, 3106–3130. [Google Scholar] [CrossRef]
- Taemeh, M.A.; Shiravandi, A.; Korayem, M.A.; Daemi, H. Fabrication challenges and trends in biomedical applications of alginate electrospun nanofibers. Carbohydr. Polym. 2020, 228, 115419. [Google Scholar] [CrossRef]
- Caló, E.; Barros, J.; Ballamy, L.; Khutoryanskiy, V.V. Poly (vinyl alcohol)–Gantrez® AN cryogels for wound care applications. RSC Adv. 2016, 6, 105487–105494. [Google Scholar] [CrossRef]
- Chen, L.; Wang, S.; Yu, Q.; Topham, P.D.; Chen, C.; Wang, L. A comprehensive review of electrospinning block copolymers. Soft Matter 2019, 15, 2490–2510. [Google Scholar] [CrossRef]
- Gule, N.P.; Bshena, O.; de Kwaadsteniet, M.; Cloete, T.E.; Klumperman, B. Immobilized Furanone Derivatives as Inhibitors for Adhesion of Bacteria on Modified Poly (styrene-co-maleic anhydride). Biomacromolecules 2012, 13, 3138–3150. [Google Scholar] [CrossRef]
- Musa, O.M. Handbook of Maleic Anhydride Based Materials, 10th ed.; Springer Nature: Basel, Switzerland, 2016; pp. 89–93. [Google Scholar] [CrossRef]
- Bag, S.; Ghosh, S.; Paul, S.; Khan ME, H.; De, P. Styrene-Maleimide/Maleic Anhydride Alternating Copolymers: Recent Advances and Future Perspectives. Macromol. Rapid Commun. 2021, 42, 2100501. [Google Scholar] [CrossRef] [PubMed]
- Tamayo, L.; Santana, P.; Forero, J.C.; Leal, M.; González, N.; Díaz, M.; Giuliani, N.; Hamm, E.; Urzúa, M. Coaxial fibers of poly (styrene-co-maleic anhydride)@ poly (vinyl alcohol) for wound dressing applications: Dual and sustained delivery of bioactive agents promoting fibroblast proliferation with reduced cell adherence. Int. J. Pharm. 2022, 611, 121292. [Google Scholar] [CrossRef]
- Cécile, C.; Hsieh, Y.L. Hydrophilic polystyrene/maleic anhydride ultrafine fibrous membranes. J. Appl. Polym. Sci. 2010, 115, 723–730. [Google Scholar] [CrossRef]
- Tamayo, L.A.; Zapata, P.A.; Vejar, N.D.; Azócar, M.I.; Gulppi, M.A.; Zhou, X.; Thompson, G.E.; Rabagliati, F.M.; Páez, M.A. Release of silver and copper nanoparticles from polyethylene nanocomposites and their penetration into Listeria monocytogenes. Mater. Sci. Eng. C 2014, 40, 24–31. [Google Scholar] [CrossRef]
- Rodríguez-Tobías, H.; Morales, G.; Ledezma, A.; Romero, J.; Grande, D. Novel antibacterial electrospun mats based on poly (d, l-lactide) nanofibers and zinc oxide nanoparticles. J. Mater. Sci. 2014, 49, 8373–8385. [Google Scholar] [CrossRef]
- Sahi, A.K.; Varshney, N.; Poddar, S.; Mahto, S.K. Comparative behaviour of electrospun nanofibers fabricated from acid and alkaline hydrolysed gelatin: Towards corneal tissue engineering. J. Polym. Res. 2020, 27, 344. [Google Scholar] [CrossRef]
- Extrand, C.W. Contact angles and hysteresis on surfaces with chemically heterogeneous islands. Langmuir 2003, 19, 3793–3796. [Google Scholar] [CrossRef]
- Aghdam, R.M.; Najarian, S.; Shakhesi, S.; Khanlari, S.; Shaabani, K.; Sharifi, S. Investigating the effect of PGA on physical and mechanical properties of electrospun PCL/PGA blend nanofibers. J. Appl. Polym. Sci. 2012, 124, 123–131. [Google Scholar] [CrossRef]
- Ritger, P.L.; Peppas, N.A. A simple equation for description of solute release I. Fickian and non-fickian release from non-swellable devices in the form of slabs, spheres, cylinders or discs. J. Control. Release 1978, 5, 23–36. [Google Scholar] [CrossRef]
- Hashem, H.M.; Motawea, A.; Kamel, A.H.; Bary, E.M.A.; Hassan, S.S.M. Fabrication and characterization of electrospun nanofibers using biocompatible polymers for the sustained release of venlafaxine. Sci. Rep. 2022, 12, 18037. [Google Scholar] [CrossRef]
- Forero, J.C.; Roa, E.; Reyes, J.G.; Acevedo, C.; Osses, N. Development of Useful Biomaterial for Bone Tissue Engineering by Incorporating Nano-Copper-Zinc Alloy (nCuZn) in Chitosan/Gelatin/Nano-Hydroxyapatite (Ch/G/nHAp) Scaffold. Materials 2017, 10, 1177. [Google Scholar] [CrossRef] [PubMed]
- Santana, P.A.; Jara-Gutiérrez, C.; Mellado, M.; Forero, J.C.; Guzmán, F.; Barriga, A.; Albericio, F.; Álvarez, C.A. Effects of elderflower extract enriched with polyphenols on antioxidant defense of salmon leukocytes. Electron. J. Biotechnol. 2021, 52, 13–20. [Google Scholar] [CrossRef]
- Torricelli, P.; Gioffrè, M.; Fiorani, A.; Panzavolta, S.; Gualandi, C.; Fini, M.; Focarete, M.L.; Bigi, A. Co-electrospun gelatin-poly (L-lactic acid) scaffolds: Modulation of mechanical properties and chondrocyte response as a function of composition. Mater. Sci. Eng. C 2014, 36, 130–138. [Google Scholar] [CrossRef] [PubMed]
- Erdem, R.; Usta, İ.; Akalin, M.; Atak, O.; Yuksek, M.; Pars, A. The impact of solvent type and mixing ratios of solvents on the properties of polyurethane based electrospun nanofibers. Appl. Surf. Sci. 2015, 334, 227–230. [Google Scholar] [CrossRef]
- Cramariuc, B.; Cramariuc, R.; Scarlet, R.; Manea, L.R.; Lupu, I.G.; Cramariuc, O. Fiber diameter in electrospinning process. J. Electrostat. 2013, 71, 189–198. [Google Scholar] [CrossRef]
- Leal, M.S.; Briones, X.; Villalobos, V.; Queneau, Y.; Leiva, A.; Rios, H.E.; Pavez, J.; Silva, C.P.; Carrasco, C.; Neira-Carrillo, A.; et al. Amino Acid-Functionalized Polyelectrolyte Films as Bioactive Surfaces for Cell Adhesion. ACS Appl. Mater. Interfaces 2019, 11, 19751–19762. [Google Scholar] [CrossRef]
- Briones, X.; Villalobos, V.; Queneau, Y.; Danna, C.S.; Muñoz, R.; Ríos, H.E.; Pavez, J.; Páez, M.; Cabrera, R.; Tamayo, L.; et al. Surfaces based on amino acid functionalized polyelectrolyte films towards active surfaces for enzyme immobilization. Mater. Sci. Eng. C 2019, 104, 109938. [Google Scholar] [CrossRef]
- Mahdavifard, S.; Sekhavatmand, N. Glutamine Is a Superior Protector Against Lead-Induced Hepatotoxicity in Rats via Antioxidant, Anti-inflammatory, and Chelating Properties. Biol. Trace Elem. Res. 2022, 200, 4726–4732. [Google Scholar] [CrossRef]
- Lacey, J.M.; Wilmore, D.W. Is glutamine a conditionally essential amino acid? Nutr. Rev. 1990, 48, 297–309. [Google Scholar] [CrossRef]
- Fildes, P.; Gladstone, G.P. Glutamine and the growth of bacteria. Br. J. Exp. Pathol. 1939, 20, 334–341. [Google Scholar]
- Para, G.M.; Baratti, J.C. Effect of culture conditions on the production of tyrosine phenol-lyase by Erwinia herbicola. Appl. Environ. Microbiol. 1984, 48, 1256–1258. [Google Scholar] [CrossRef] [PubMed]
- Enei, H.; Matsui, H.; Yamashita, K.; Okumura, S.; Yamada, H. Distribution of tyrosine phenol lyase in microorganisms. Chem. Biol. Technol. Agric. 1972, 36, 1861–1868. [Google Scholar] [CrossRef]
- Davies, K.J. The broad spectrum of responses to oxidants in proliferating cells: A new paradigm for oxidative stress. IUBMB Life 1999, 48, 41–47. [Google Scholar] [CrossRef] [PubMed]
- Morimoto, Y.; Tanaka, K.; Iwakiri, Y.; Tokuhiro, S.; Fukushima, S.; Takeuchi, Y. Protective effects of some neutral amino acids against hypotonic hemolysis. Biol. Pharm. Bull. 1995, 18, 1417–1422. [Google Scholar] [CrossRef] [PubMed]

| Model | Param. | PSMA | PSMA-Gln | PSMA-Phe | PSMA-Tyr | ||||
|---|---|---|---|---|---|---|---|---|---|
| 0.5% | 2.0% | 0.5% | 2.0% | 0.5% | 2.0% | 0.5% | 2.0% | ||
| Zero-order | C0 | - | - | - | - | −(0.0128) | −(0.0219) | - | - |
| K0 | 0.167 | 0.448 | 0.0240 | 0.0829 | 0.00305 (0.000530) | 0.0216 (0.0173) | 0.0370 | 0.0410 (0.0323) | |
| R2 | 0.947 | 0.954 | 0.861 | 0.690 | −0.570 (0.979) | 0.933 (0.988) | 0.868 | 0.931 (0.960) | |
| First-order | C1 | 134 | 3003 | 0.164 | 0.471 | 0.266 | 0.224 | 0.255 | 33.1 (0.210) |
| K1 | 0.00125 | 0.000149 | 0.312 | 0.585 | 0.0117 | 0.141 | 0.305 | 0.00124 (0.249) | |
| R2 | 0.947 | 0.954 | 0.963 | 0.951 | −0.538 | 0.956 | 0.965 | 0.930 (0.998) | |
| Higuchi | KH | 0.360 | 0.961 | 0.0554 | 0.195 | 0.00764 | 0.0489 | 0.0853 | 0.0887 (0.0621) |
| R2 | 0.790 | 0.774 | 0.989 | 0.984 | 0.412 | 0.952 | 0.989 | 0.774 (0.946) | |
| Korsmeyer–Peppas | n | 1.13 | 1.34 | 0.544 | 0.412 | 0.0882 | 0.679 | 0.552 | 1.42 (0.737) |
| KKP | 0.134 | 0.250 | 0.052 | 0.222 | 0.0136 | 0.0372 | 0.0789 | 0.0194 (0.0467) | |
| R2 | 0.941 | 0.969 | 0.984 | 0.992 | 0.925 | 0.964 | 0.985 | 0.940 (0.989) | |
Disclaimer/Publisher’s Note: The statements, opinions and data contained in all publications are solely those of the individual author(s) and contributor(s) and not of MDPI and/or the editor(s). MDPI and/or the editor(s) disclaim responsibility for any injury to people or property resulting from any ideas, methods, instructions or products referred to in the content. |
© 2023 by the authors. Licensee MDPI, Basel, Switzerland. This article is an open access article distributed under the terms and conditions of the Creative Commons Attribution (CC BY) license (https://creativecommons.org/licenses/by/4.0/).
Share and Cite
Santander, S.; Padilla-Manzano, N.; Díaz, B.; Bacchiega, R.; Jara, E.; Álvarez, L.F.; Pinto, C.; Forero, J.C.; Santana, P.; Hamm, E.; et al. Wettability of Amino Acid-Functionalized PSMA Electrospun Fibers for the Modulated Release of Active Agents and Its Effect on Their Bioactivity. Pharmaceutics 2023, 15, 1659. https://doi.org/10.3390/pharmaceutics15061659
Santander S, Padilla-Manzano N, Díaz B, Bacchiega R, Jara E, Álvarez LF, Pinto C, Forero JC, Santana P, Hamm E, et al. Wettability of Amino Acid-Functionalized PSMA Electrospun Fibers for the Modulated Release of Active Agents and Its Effect on Their Bioactivity. Pharmaceutics. 2023; 15(6):1659. https://doi.org/10.3390/pharmaceutics15061659
Chicago/Turabian StyleSantander, Sebastián, Nicolás Padilla-Manzano, Bastián Díaz, Renato Bacchiega, Elizabeth Jara, Luis Felipe Álvarez, Cristóbal Pinto, Juan C. Forero, Paula Santana, Eugenio Hamm, and et al. 2023. "Wettability of Amino Acid-Functionalized PSMA Electrospun Fibers for the Modulated Release of Active Agents and Its Effect on Their Bioactivity" Pharmaceutics 15, no. 6: 1659. https://doi.org/10.3390/pharmaceutics15061659
APA StyleSantander, S., Padilla-Manzano, N., Díaz, B., Bacchiega, R., Jara, E., Álvarez, L. F., Pinto, C., Forero, J. C., Santana, P., Hamm, E., Urzúa, M., & Tamayo, L. (2023). Wettability of Amino Acid-Functionalized PSMA Electrospun Fibers for the Modulated Release of Active Agents and Its Effect on Their Bioactivity. Pharmaceutics, 15(6), 1659. https://doi.org/10.3390/pharmaceutics15061659

